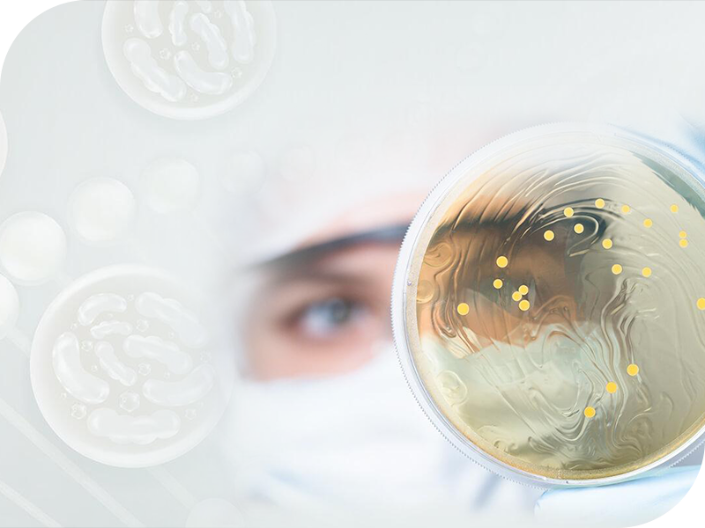

Women’s Health Ingredients for Global Formulators
From microbiome balance to hormonal rhythm, we provide professional support for women’s comprehensive health needs.
At New Bellus, we leverage science-based innovation to deliver standardized ingredients, complete technical dossiers, and ready-to-use formulations—helping brands accelerate product development that meets global women’s health trends.
Our solutions cover the full spectrum, from daily wellness to menopause support, with a strong focus on safety, functionality, and market differentiation.
Challenges & Solutions
Microbiome Imbalance
Solution A
A busy lifestyle and irregular diet can easily disrupt gut and intimate microbiota balance.
Solution A|Intimate & Urinary Care|Functional Probiotics + Postbiotics
- Multi-strain Functional Probiotics formula, combined with Patented 5-layer embedding technology, helps maintain gut microbiota balance and effectively increases beneficial bacteria.
- Improves the intimate micro-environment by inhibiting harmful bacteria growth, reducing the risk of infection and discomfort.
- Pre-clinically supported to maintain urinary and intimate health, improving daily comfort.
Hormonal Fluctuations
Solution B
Menstrual cycles and menopause often bring emotional, sleep, and metabolic challenges.
Solution B|Hormonal Rhythm & Comfort|Brazil Mushroom Mycelium +
New Bellus PostbioGABATM
- Rich in natural polysaccharides and L-Pyroglutamic acid, gently supporting mind-body balance.
- Helps improve menstrual comfort and emotional stability during menopause.
- Can be fortified with New Bellus PostbioGABATM, naturally rich in GABA, to support restful sleep and emotional stability.
Beauty from Within
Solution C
Desire for radiant skin and stable complexion, without high sugar or high calories.
Solution C|Inner Beauty Care|Fermented Berries & Phytochemicals
- 4-stage fermentation process releasing polyphenols and SOD-like activity, enhancing antioxidant capacity.
- Through the gut–skin axis, beneficial metabolites are delivered to the skin, helping maintain a clear and healthy complexion.
- Refreshing, low-calorie, and alcohol-free—beauty and health in balance.
Stress & Metabolic Burden
Solution D
Modern women juggle work and life, often impacting emotional resilience and metabolism.
Solution D|Emotional Resilience × Metabolic Support|Fermented Ginseng/Notoginseng + Postbiotics
- Biotransforming-techTM microbial fermentation produces Rg₅ / Rg₃ / RK₁, supporting mood regulation and metabolism.
- Meets international clean-label standards: Vegan, Non-GMO, Dairy-free, Gluten-free, Soy-free.
Application Scenarios
Women’s health solutions tailored for every stage of life
01
Daily Wellness
Maintain gut and intimate balance for comfort and lightness.
02
Cycle Management
Relieve PMS discomfort, mood swings, and bloating for a more comfortable period.
03
Menopause Support
Improve hot flashes and sleep quality to stay energetic and agile.
04
Stress Adaptation
Manage daily stress, helping stabilize emotions and enhance focus.
05
Fitness & Body Management
Pair with exercise to maintain strength and a healthy body composition.
06
Ageless Beauty
Antioxidant support from within, keeping skin radiant and confidence glowing.
Probio-U
Best for those susceptible to urinary tract infections (UTIs) or seeking to maintain urinary health; suitable for women prone to recurrent UTIs.
FEATURE
- Patented Strains
- Preclinical Trials
- Patented 5-Layer Embedding
- Vegan, Non-GMO, Dairy-free, Gluten-Free, Soy-free, Halal
PRODUCT INFORMATION
- Strain composition: Lactobacillus plantarum LP142, Pediococcus pentosaceus PP365, Pediococcus pentosaceus PP366.
- Application: Improve vaginosis & urinary tract infection.
Brazil mushroom
Agaricus subrufescens
Empower your inner strength with Brazil Mushroom, designed for women's unique health needs.
FEATURE
- Patented submerged fermentation technology
- Passed multiple hygiene and safety assessments
- Non-GMO, Vegan, Halal
PRODUCT INFORMATION
- Active Substances: Polysaccharides, L-Pyroglutamic acid.
- Application: Relieves menstrual discomfort, Alleviates menopause symptoms.
Fermented Berries
Unlock the secret to ageless beauty and urogenital health with antioxidant-rich fermented berries.
FEATURE
- Patented submerged fermentation technology
- Biotransforming-techTM: Microbial transformation technology
- Unique four-stage fermentation process
- Fermentation materials included 10 kinds of berries
- No artificial additives and preservatives
- Low calorie and no alcohol residue
- Pass multiple hygiene and safety assessments
- Compliant with the regulations of (EU) 2023/915 on the maximum levels of certain contaminants in food
- Vegan, Non-GMO, Dairy-free, Gluten-Free, Soy-free, Halal
PRODUCT INFORMATION
- Active Substances: DPPH, SOD-like, Acetic acid, Butyric acid, Polyphenols, Postbiotics.
- Application: Enhance natural beauty, Supports urogenital system, Anti-aging and scavenge free radicals.
Fermented Notoginseng Powder
Support anti-aging, beauty, and immune regulation for women and seniors with Fermented Notoginseng.
FEATURE
- Patented submerged fermentation technology
- Biotransforming-techTM: Microbial transformation technology
- Clear and definite active substances
- Pass multiple hygiene and safety assessments
- Non Heavy Metal and Pesticide Residues
- Compliant with the regulations of (EU) 2023/915 on the maximum levels of certain contaminants in food
- Vegan, Non-GMO, Dairy-free, Gluten-Free, Soy-free, Halal
PRODUCT INFORMATION
- Active Substances: Ginsenoside Rg3, Ginsenoside Rg5, Ginsenoside RK₁,
Heat-treated probiotics (Postbiotics).
- Application: Anti-aging, Beauty effect, Anti-depression, Anti-arthritis, Liver protection, Anti-allergy, Immune regulation, Anti-virus.
Learn more Fermented Notoginseng Powder Ingredients information
Fermented Ginsenoside Rg5
Enhance memory and detoxify with Ginsenoside Rg5
, supporting weight management, nerve protection, and joint health.
FEATURE
- Patented submerged fermentation technology
- Biotransforming-techTM: Microbial transformation technology
- Clear and definite active substances
- Pass multiple hygiene and safety assessments
- Non Heavy Metal and Pesticide Residues
- Compliant with the regulations of (EU) 2023/915 on the maximum levels of certain contaminants in food
- Vegan, Non-GMO, Dairy-free, Gluten-Free, Soy-free
PRODUCT INFORMATION
- Active Substances: Ginsenoside Rg5
.
- Application: Anti-obesity, Memory improvement, Nerve protection, Detoxification, Anti-arthritis.



